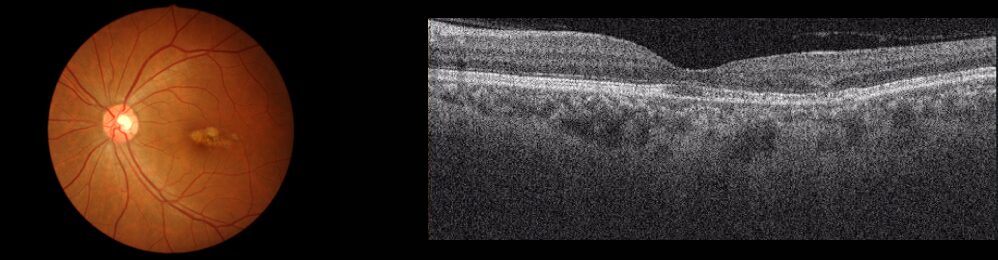
萎縮型
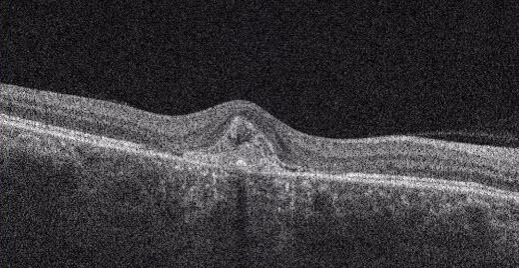
三次元眼底画像解析装置(OCT)

加齢黄斑変性とは?
網膜の中心にある黄に障害を生じ、見ようとするところが見にくくなる病気です。年齢を重ねるにしたがって、黄斑部も徐々に変化していき、発症の危険性が増します。50歳以上の方で男性の方が多いことがわかっています。
加齢黄斑変性になりやすいのは?
遺伝的になりやすい体質があることがわかっています。
- タバコを吸っている方
- 野外で日光に当たることが多い方
- 食生活のバランスが偏っている方
などに起こりやすいです。
加齢黄斑変性の分類
大きく分けると滲出型と萎縮型の2種類があります。
滲出型
新生血管が出来て、そこから出血したり、液体成分が流れ出したりすることで黄斑部にむくみが出ることが多いです。日本人の患者さんの約9割がこのタイプです。進行が比較的速く、見つかった時点ですぐ治療をする必要があります。

萎縮型
黄斑部ににたまった老廃物が網膜を萎縮させることで起こります。日本人の加齢黄斑変性全体の約1割と滲出型に比べて、少ないです。進行は遅く、視力の低下もゆっくりです。経過観察と生活習慣の改善が望ましいです。
前駆病変ドルーゼン
加齢黄斑変性になる前段階として、黄斑部に老廃物がたまっている状態です。この場合も経過観察と生活習慣の改善が望ましいです。

加齢黄斑変性の症状
- 視力の低下
- 見たいところがぼやける
- 見たいところがゆがんで見える
- 物がゆがんで見える
加齢黄斑変性の検査
01.三次元眼底画像解析装置(OCT)
網膜の断面を観察して、網膜やその下の新生血管などの状態を立体的に観察します。
02.OCTアンギオグラフィー(OCTA)

造影剤を用いることなく、網膜・脈絡膜血管内の血液の様子を可視化することのできます。
加齢黄斑変性の治療
萎縮型加齢黄斑変性
治療法は今のところありません。
滲出型加齢黄斑変性
治療の目的は新生血管の拡大を抑え、萎縮させて視力の維持をすることです。
抗VEGF注射
脈絡膜新生血管ができるのには、血管内皮増殖因子(VEGF)が関係していると言われています。
VEGFを阻害することによって、新生血管を退縮させる方法です。
- ルセンティス
- ラニビズマブBS
- アイリーア
- ベオビュ
- バビースモ
が認定されています。
基本的には目の中に4週間ごとに3回注射します。
その後は新生血管の活動性が見られれば、再度注射をします。
注射の詳細は黄斑疾患治療のページをご覧ください。
加齢黄斑変性の予防
- 禁煙
タバコを吸う人は加齢黄斑変性になる危険性が高いです。禁煙をお勧めします。 - サプリメント
ビタミンンC・ビタミンE・βカロチン・亜鉛などを含むサプリメントを飲むと加齢黄斑変性の発症が少なくなることがわかっています。 - 緑黄色野菜・魚中心の食事
- 直射日光をさける
帽子やサングラスをかけましょう。
加齢黄斑変性は両眼に起こることも多い病気です。
毎日どこか見るところ決めて(カレンダー、お風呂のタイルなど)片目ずつ歪みがないか、見えないところがないか確認しましょう。
加齢黄斑変性よくある質問
予防法を教えてください。
直射日光を避け、喫煙している方は禁煙をお勧めします。緑色野菜や魚を中心とした食事を摂るよう心掛けてください。
抗VEGF注射を打つことで視力は上がりますか?
発症して早期に治療をすれば、病変が改善され、見え方も良くなることはあります。しかし治療が遅れると、視力を維持することが難しく、ゆがみや真ん中が暗く見えるなどの自覚症状が残ります。視力低下を抑えるには、早期発見・早期治療が何より大切です。
もう片方の眼に発症する可能性はありますか?
両眼に発症する可能性は20%くらいあります。片方の眼だけだからと油断しないで、最善の治療を受けておくことが大切です
眼に直接注射するのは怖いですが、大丈夫でしょうか?
痛みもほとんどありません。終わってみると「意外に平気だった」とおっしゃる方が多いです。
抗VEGF注射の治療はいつまで受け続ければいいのでしょうか?金額が高額なので心配です。
抗VEGF注射は基本的には継続して行いますが、経過から判断して、治療の間隔を伸ばしていきます。
治療費が高く、経済的な負担が大きいです。どうにか負担を減らすことはできないでしょうか?
比較的、経済的な負担を軽くすることができる薬もあります。主治医とご相談してください。
高額療養費制度を使うことも可能です。積極的に利用してください。高額療養費制度は医療機関で支払った金額が1ヶ月の間に上限額をを超えた場合、超えた金額が後払いされる方法です。上限額は年齢や所得によって異なります。健康保険組合や市区町村などにお問い合わせください。詳しくは厚生労働省ホームページ「高額療養費制度を利用する皆さんへ」をご覧ください。
抗VEGF注射で副作用や合併症が出ることはありますか?
注射後は一時的に見にくくなることもあります。感染症である眼内炎には注意が必要です。気になる症状があれば、すぐにご相談ください。
